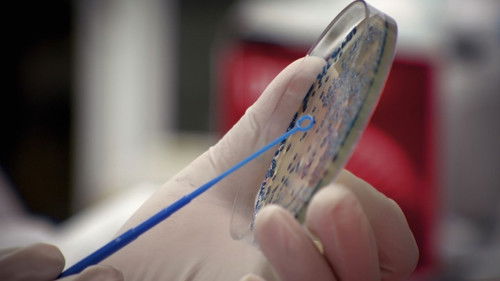
Episode 3

Sezoni 1
Sezoni 1
3 Episodet
2021
Episodet e Sezonit 1
3 episodet
E1
Airborne Attack
55min
Transmetuar më: 05 April 2021
Dr Norman Swan uncovers the gripping stories and life-changing scientific breakthroughs from our past clashes with deadly respiratory viruses.

E2
Creatures of Contagion
55min
Transmetuar më: 12 April 2021
Dr Norman Swan presents the compelling stories of scientists, doctors and public health experts who fight the deadly viruses that cross-over from animals to humans.
E3
The Superbug Era
55min
Transmetuar më: 19 April 2021
Dr Norman Swan speaks with leading doctors and scientists from around the world sounding the alarm about superbugs, a microbial threat that many predict will be worse than the COVID-19 pandemic.